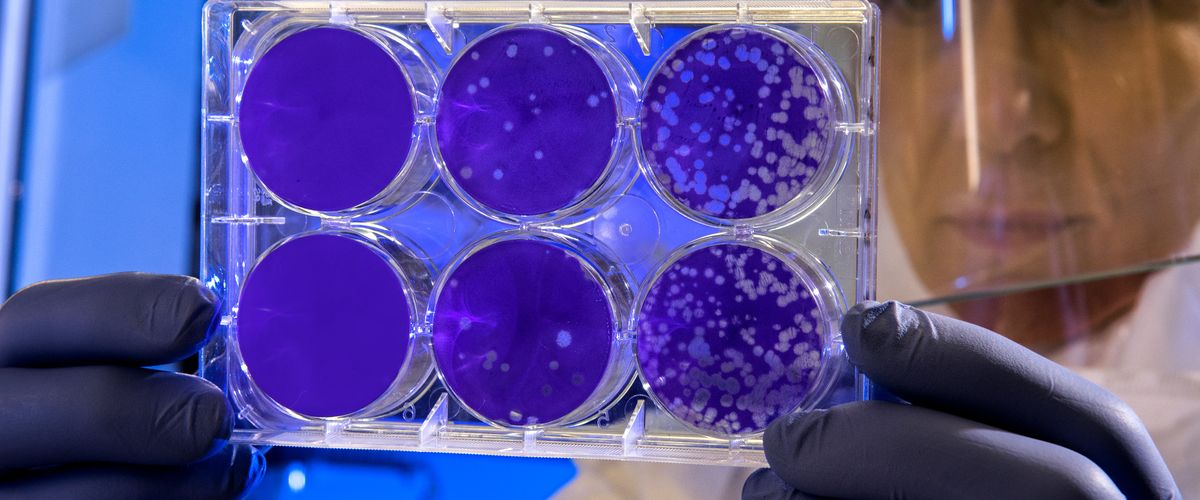

Landing Page Template
This page is a demonstration of the BU Landing Pages plugin. This is the standard content area, and if there’s anything here, it’ll show above the BU Landing Pages plugin content.
When editing a page, all you need to do to enable the BU Landing Pages plugin content is select “Landing Page” as the page template and then save the page. This will work on any page, including the homepage.
Everything below this, starting with the gray “Promo Space 1” area, is part of the BU Landing Pages plugin content.